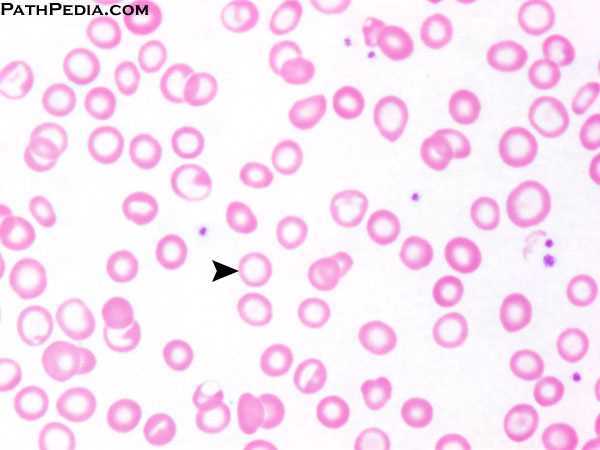

Qual a clínica da síndrome carencial?
Qual a clínica da carência nutricional?
Qual a clínica da carência de ferro?
Como está a ferritina?
Redução da ferritina <30 (Normal: 30-100ng/mL)
Como está a transferrina e o TIBC?
Aumento de transferrina e aumento de TIBC > 360 (N: 250-360 mcg/dL)
Como está o ferro sérico?
Redução de ferro sérico < 30 (N: 60-150 mcg/dL)
Como está a saturação de transferrina?
Redução da saturação de transferrina < 10% (N: 20-40%)
HMG clássico
Anemia Micro/Hipo
Como está o RDW?
Aumentado
Como estão as plaquetas?
Aumentadas
Qual o marcador mais precoce de resposta à reposição de ferro na anemia ferropriva?
RETICULOCITOSE
Começa no 2º dia, pico no 7º dia até o 10º dia
Duração do tratamento
Fazer por + 6 meses após correção da anemia, OU Ferritina > 15-50 ng/mL
Qual a primeira alteração hematológica na anemia ferropriva?
ANEMIA NORMOCÔMICA NORMOCÍTICA
Qual o primeiro parâmetro da hematoscopia a se aleterar na anemia ferropriva?
E depois?
MICROCÍTICA
… e depois ….
HIPOCRÔMICA (a última a aparecer)
Qual a primeira alteração hematológica na anemia ferropriva?
ANEMIA NORMOCÔMICA NORMOCÍTICA
Qual o primeiro parâmetro da hematoscopia a se aleterar na anemia ferropriva?
E depois?
MICROCÍTICA
… e depois ….
HIPOCRÔMICA (a última a aparecer)
Principais causas de anemia ferropriva em CRIANÇAS?

Principais causas de anemia ferropriva em ADULTOS?
Como investigar?
TODO indivíduo > 50 anos com deficiência de ferro = E.D.A e COLONOSCOPIA!!

Como é o tratamento da anemia ferropriva?
Dose e posologia?
SULFATO FERROSO
300 mg (60 mg Fe elementar) 3x/dia
Ingerir longe das refeições / de preferência com algo ácido

Qual o marcador mais precoce de resposta à reposição de ferro na anemia ferropriva?
RETICULOCITOSE
Começa no 2º dia, pico no 7º dia até o 10º dia

Quanto tempo deve durar o tratamento da anemia ferropriva?
Manter por 6 meses a 1 ano após normalizar Hb
Ou até níveis de ferritina > 50 ng/mL
Qual o principal marcador visto no hemograma que diferencia anemia FERROPRIVA da TALASSEMIA MINOR?
FERROPRIVA = ↑ RDW
TALASSEMIA = RDW normal